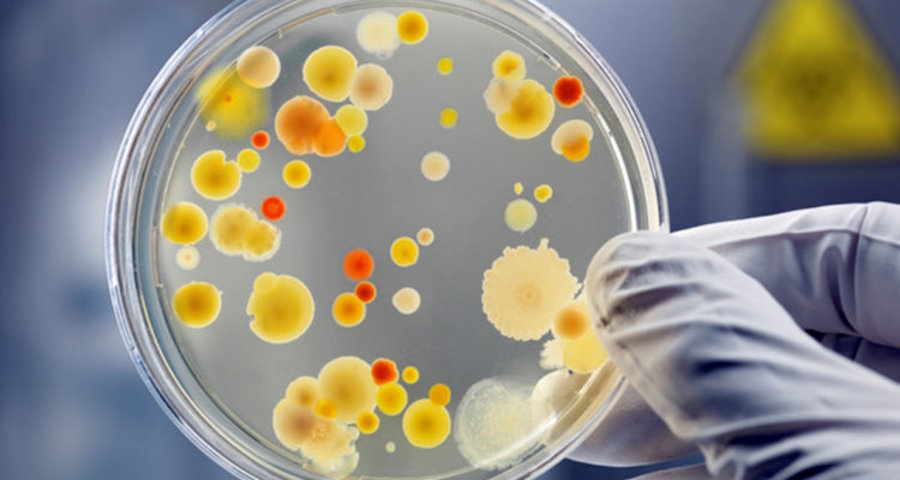
ротавірусна інфекція

Лише за перші чотири місяці року в Україні зареєстровано майже 16 тисяч випадків ГКІ, і це ще не межа
Літо – традиційний сезон гострих кишкових інфекцій, причому зустрітися з патогеном можна у таких місцях, про які ви навіть не думаєте.
Чим отруєння відрізняється від інфекції, як уберегтися від ГКІ та за яких симптомів потрібно негайно звернутися до лікаря – розповідає Каштан NEWS.

Чому саме влітку
Загалом гострі кишкові інфекції (ГКІ) нікуди не діваються протягом усього року. За статистикою Центру громадського здоров’я, лише з січня до квітня в Україні було зареєстровано майже 16 тисяч випадків. Однак активізація кишкових інфекцій завжди припадає на теплий сезон, тож пік захворюваності в нас ще попереду.
Чому так відбувається:
- високі температури сприяють псуванню продуктів та розмноженню у них патогенних організмів;
- люди їдять більше свіжих овочів, фруктів та ягід, які в немитому вигляді легко стають джерелом передачі інфекції;
- у спеку підвищується споживання води та інших напоїв, а це зменшує концентрацію шлункового соку, який є природнім нейтралізатором патогенів;
- активізуються комахи (насамперед мухи), які є переносниками збудників ГКІ;
- розпочинається купальний сезон, тож відповідно підвищується ризик зараження через брудну воду у водоймах;
- улітку люди частіше подорожують, що сприяє поширенню інфекцій (ГКІ швидко передаються від людини до людини).
Загалом відомо кілька десятків гострих кишкових інфекцій. Вони можуть викликатися різними збудниками – вірусами (ротавірус, ентеровіруси, аденовіруси кишкової групи), бактеріями (кишкова паличка, холерний вібріон, стафілокок, сальмонела) або найпростішими (амеби, лямблії). ГКІ є так званими «хворобами брудних рук», тобто передаються орально-фекальним шляхом.
Отруїлися чи заразилися?
У побуті ми часто називаємо гострі кишкові інфекції отруєннями, однак між ними є різниця: ГКІ викликаються власне патогенними організмами, а харчові отруєння – токсинами, які ці організми виділяють у харчових продуктах. Найбільш поширеною причиною отруєнь є стафілокок: він здатен виробляти ентеротоксини у харчових продуктах – сирах, соусах, рибних та м’ясних стравах, але найчастіше – в кондитерських виробах із кремом.

Симптоми кишкових інфекцій та харчових отруєнь здебільшого дуже схожі. Насамперед, це:
- діарея;
- нудота, блювання;
- біль та/або здуття в животі;
- слабкість;
- часто – головний біль, підвищена температура;
- ознаки зневоднення: сухість у роті та горлі, незначне сечовипускання або його повна відсутність.
При підвищенні температури, болю в животі та ознаках зневоднення потрібно негайно звернутися до лікаря: такий стан може бути небезпечним для життя.
Якими бувають гострі кишкові інфекції
Безперечний «лідер» серед ГКІ за захворюваністю – це ротавірусна інфекція. Переважна більшість людей встигає вперше перехворіти на неї ще в ранньому дитинстві – до п’яти років. У маленьких дітей ротавірусна інфекція викликає блювання та сильну діарею, яка може тривати від чотирьох до восьми днів. Для дитячого організму такий стан є дуже небезпечним: у дітей швидко розвивається зневоднення, і без лікування дитина може загинути.
У дітей більш старшого віку та дорослих за рахунок надбаного імунітету захворювання зазвичай перебігає значно легше або й зовсім безсимптомно. Але навіть безсимптомні хворі є носіями інфекції і можуть легко заразити нею оточуючих. Також ротавірусна інфекція є небезпечною для дорослих з груп ризику – людей похилого віку та людей із ослабленим імунітетом.
Дуже схожою за проявами є й норовірусна інфекція, яка також найбільш яскраво перебігає у дітей, а в дорослих може зустрічатися у безсимптомному вигляді.

Ще одне розповсюджене «літнє» захворювання – сальмонельоз. Його збудниками є сальмонели – бактерії, які частіше за все зустрічаються в м’ясі та м’ясних виробах (особливо у фарші). Також «домівкою» для сальмонел можуть бути риба, морепродукти, яйця та вироби з яєць, молоко та молокопродукти. Крім того, сальмонельозом можна заразитися контактно-побутовим шляхом від людини-носія або через заражені поверхні. Захворювання починається з підвищення температури, сильного болю в животі та блювання. Пізніше до блювання приєднується сильний пронос із слизистими випорожненнями зеленуватого відтінку та зневоднення – сухість у роті, відчуття спраги, м’язова слабкість та судоми литкових м’язів.
Інтенсивний пронос із домішками крові також може бути симптомом шигельозу (дизентерії) – захворювання, яке спричиняють бактерії роду Shigella (дизентерійна паличка). Збудник передається через немиті свіжі харчі, брудну воду, інфіковані поверхні або від людини до людини. Для шигельозу характерне дуже значне підвищення температури (до 39-40 °С і більше), спазми та сильний, часто нестерпний біль у животі, випорожнення з домішками слизу, крові і нерідко – гною. Найбільш небезпечним шигельоз є для дітей до трьох років, людей похилого віку та людей із хронічними захворюваннями.

А от при стафілококовому харчовому отруєнні проносу може і не бути, проте спостерігаються нудота, часте блювання, сильний біль у верхній половині живота та головний біль. Інкубаційний період дуже короткий – від споживання харчів, заражених токсинами, до появи перших симптомів може пройти від 15 хвилин до шести годин. Через значну інтоксикацію може розвинутися гостра судинна недостатність, яка є вкрай небезпечною для життя.
Як уберегтися від кишкових інфекцій та отруєнь
Загальні рекомендації – дотримуватися правил особистої гігієни та обробки харчів, а також уникати місць, де ризик інфікування є підвищеним. Ось рекомендації Міністерства охорони здоров’я, які допоможуть вам зберегти своє здоров’я влітку.
- Ретельно мийте руки з милом після вулиці, відвідування туалету, перед їжею та приготуванням їжі. Обов’язково привчіть до цього ваших дітей.
- Зберігайте чистоту кухонного приладдя та поверхонь.
- Ретельно мийте фрукти та овочі проточною чистою водою.
- Не споживайте прострочені харчі або такі, які зберігалися неналежним чином.
- Не нехтуйте термічною обробкою харчів тваринного походження, не вживайте сирі або напівсирі м’ясо та рибу, сирі яйця.
- Не зберігайте приготовлену їжу за кімнатної температури більше двох годин.
- Не вживайте некип’ячену воду або воду з відкритих водойм.
- Купайтеся лише на офіційних пляжах і лише в тому випадку, якщо їхній санітарно-епідемічний стан це дозволяє (нагадаємо, МОЗ регулярно моніторить київські пляжі, і за результатами цього моніторингу далеко не всі з них виявляються безпечними).
Костянтин МИХАЙЛЕНКО
Більше новин, фото та відео у телеграм-каналі
KASHTAN NEWS. Досі не підписані на новини Києва та України в телеграмі? Підписуйтеся та першими дізнавайтеся про найголовніше в телеграмі.